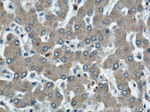
SMN Antibody in Immunohistochemistry (Paraffin) (IHC (P))

Search
Proteintech
SMN Monoclonal Antibody (2C6D9)
{{$productOrderCtrl.translations['antibody.pdp.commerceCard.promotion.promotions']}}
{{$productOrderCtrl.translations['antibody.pdp.commerceCard.promotion.viewpromo']}}
{{$productOrderCtrl.translations['antibody.pdp.commerceCard.promotion.promocode']}}: {{promo.promoCode}} {{promo.promoTitle}} {{promo.promoDescription}}. {{$productOrderCtrl.translations['antibody.pdp.commerceCard.promotion.learnmore']}}
产品信息
60154-1-IG
种属反应
宿主/亚型
分类
类型
克隆号
抗原
偶联物
形式
浓度
纯化类型
保存液
内含物
保存条件
运输条件
产品详细信息
This antibody 60154-1-Ig is specific to human SMN2. It can't recognize mouse and rat SMN.
Immunogen sequence: MAMSSGGSG GGVPEQEDSV LFRRGTGQSD DSDIWDDTAL IKAYDKAVAS FKHALKNGDI CETSGKPKTT PKRKPAKKNK SQKKNTAASL QQWKVGDKCS AIWSEDGCIY PATIASIDFK RETCVVVYTG YGNREEQNLS DLLSPICEVA NNIEQNAQEN ENESQVSTDE SENSRSPGNK SDNIKPKSAP WNSFLPPPPP MPGPRLGPGK PGLKFNGPPP PPPPPPPHLL SCWLPPFPSG PPIIPPPPPI CPDSLDDADA LGSMLISWYM SGYHTGYYME MLA (1-282 aa encoded by BC000908)
靶标信息
The SMN1 gene is part of a 500 kb inverted duplication on chromosome 5q13. This duplicated region contains at least four genes and repetitive elements which make it prone to rearrangements and deletions. The repetitiveness and complexity of the sequence have also caused difficulty in determining the organization of this genomic region. The telomeric and centromeric copies of this gene are nearly identical and encode the same protein - survival motor neuron protein. The SMN complex plays a catalyst role in the assemble of small nuclear ribonucleoproteins, the building blocks of the spliceosome. Mutations in the SMN1 gene are known to cause spinal muscular atrophy 1/2.
仅用于科研。不用于诊断过程。未经明确授权不得转售。
生物信息学
蛋白别名: Component of gems 1; Gemin-1; survival motor neuron 1 protein; Survival motor neuron protein; tudor domain containing 16A
基因别名: BCD541; GEMIN1; SMA; SMA1; SMA2; SMA3; SMA4; SMA@; SMN; SMN1; SMN2; SMNC; SMNT; T-BCD541; TDRD16A
UniProt ID: (Human) Q16637
Entrez Gene ID: (Human) 6606